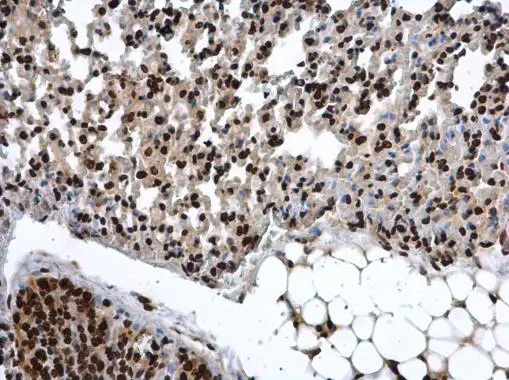
COMMD7 antibody detects COMMD7 protein at nucleus in mouse lung by immunohistochemical analysis. Sample: Paraffin-embedded mouse lung. COMMD7 antibody (GTX112076) diluted at 1:500. 
 Antigen Retrieval: Citrate buffer, pH 6.0, 15 min

COMMD7 antibody detects Commd7 protein on zebrafish by whole mount immunohistochemical analysis. Sample: 2 days-post-fertilization zebrafish embryo. COMMD7 antibody (GTX112076) dilution: 1:100.
COMMD7 antibody
GTX112076
ApplicationsImmunoFluorescence, Western Blot, ImmunoCytoChemistry, ImmunoHistoChemistry, ImmunoHistoChemistry Paraffin
Product group Antibodies
ReactivityHuman, Mouse, Zebra Fish
TargetCOMMD7
Overview
- SupplierGeneTex
- Product NameCOMMD7 antibody
- Delivery Days Customer9
- Application Supplier NoteWB: 1:500-1:3000. ICC/IF: 1:100-1:1000. IHC-P: 1:100-1:1000. *Optimal dilutions/concentrations should be determined by the researcher.Not tested in other applications.
- ApplicationsImmunoFluorescence, Western Blot, ImmunoCytoChemistry, ImmunoHistoChemistry, ImmunoHistoChemistry Paraffin
- CertificationResearch Use Only
- ClonalityPolyclonal
- Concentration1 mg/ml
- ConjugateUnconjugated
- Gene ID149951
- Target nameCOMMD7
- Target descriptionCOMM domain containing 7
- Target synonymsC20orf92, dJ1085F17.3, COMM domain-containing protein 7
- HostRabbit
- IsotypeIgG
- Protein IDQ86VX2
- Protein NameCOMM domain-containing protein 7
- ReactivityHuman, Mouse, Zebra Fish
- Storage Instruction-20°C or -80°C,2°C to 8°C
- UNSPSC41116161